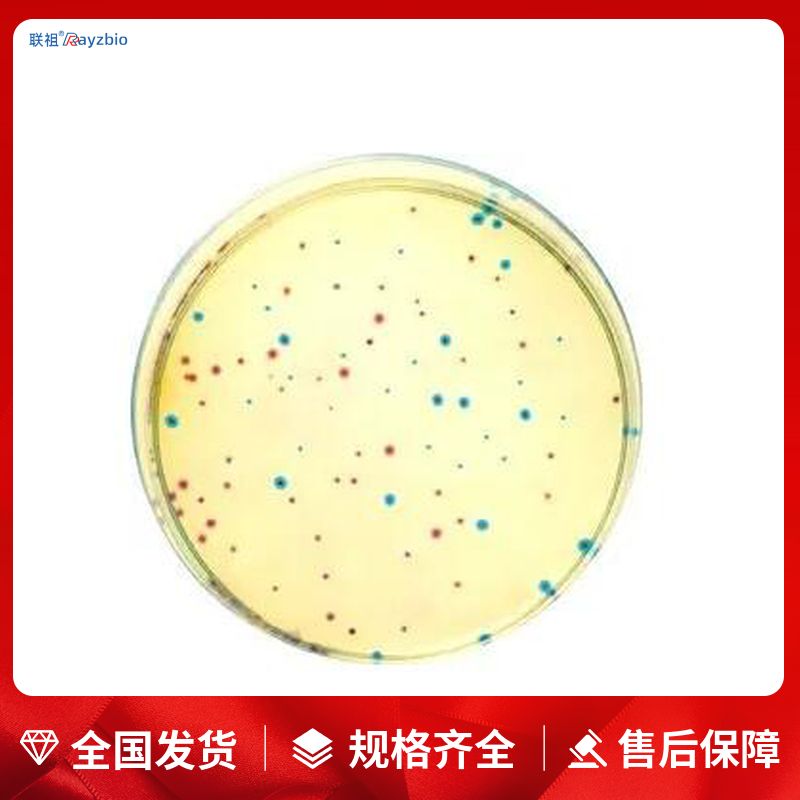
DO Supplement(五缺:Arg/His/Leu/Lys/Ura)

相关产品推荐更多 >
万千商家帮你免费找货
0 人在求购买到急需产品
- 详细信息
- 技术资料
- 库存:
53
- 英文名:
Dropout Supplement -Arg/-His/-Leu/-Lys/-Ura
- 供应商:
上海联祖
- 规格:
20g
中文名称:DO Supplement(五缺:Arg/His/Leu/Lys/Ura)
英文名称:Dropout Supplement -Arg/-His/-Leu/-Lys/-Ura
产品规格:20g
发货周期:1~3天
产品价格:询价
| 货号 | 规格 | 发货期 | 用途 |
| LZ-PYJ4902 | 20g | 1~3天 | 仅供科研实验 |
DO Supplement中缺失特定的氨基酸或核苷酸,如DO supplement -Arg/-His/-Leu/-Lys/-Ura含有除精氨酸、组氨酸、亮氨酸、赖氨酸、尿嘧啶外的各种必需氨基酸和核苷酸。
DO Supplement缺陷型氨基酸混合物主要用于酵母双杂交、酵母单杂交和酵母三杂交筛选营养缺陷型表型的酵母转化株,以及作为大批量筛选培养酿酒酵母的培养基。DO Supplement也可以添加到minimal E.coli medium M9中组成E.coli的筛选培养基。
产品组分
DO Supplement(五缺:Arg/His/Leu/Lys/Ura) 20g
说明书 1份
保存:2~8℃
配制方法
SD Broth配制方法:
称取26.7g的Minimal SD Base和相应量的DO Supplement(参照标签信息),加去离子水定容至1L,搅拌溶解。
调节pH至5.8。上述两者均为本司产品可不用调pH。
推荐115℃高压灭菌20min。
4℃冰箱避光储存已经灭菌的液体培养基。
SD with Agar平板配制方法:
称取46.7g的Minimal SD Agar Base和相应量的DO Supplement(参照标签信息),加去离子水定容至1L,搅拌助溶(琼脂在高温灭菌后溶解)。
调节pH至5.8。上述两者均为本司产品可不用调pH。
推荐115℃高压灭菌20min。
冷却到60℃把培养基倒入平板中,室温凝固,封口膜封好后倒置保存在4℃冰箱备用。
如何配置培养基:
1、配制溶液
向容器内加入所需水量的一部分,按照培养基的配方,称取各种原料,依次加入使其溶解,最后补足所需水分。对蛋白胨、肉膏等物质,需加热溶解,加热过程所蒸发的水分,应在全部原料溶解后加水补足。
2、调节pH值
用pH试纸(或pH电位计、氢离子浓度比色计)测试培养基的pH值,如不符合需要,可用10%HCl或10%NaOH进行调节,直到调节到配方要求的pH值为止。
3、过滤
用滤纸、纱布或棉花趁热将已配好的培养基过滤。用纱布过滤时,最好折叠成六层,用滤纸过滤时,可将滤纸折叠成瓦棱形,铺在漏斗上过滤。
4、分装
已过滤的培养基应进行分装。如果要制作斜面培养基,须将培养基分装于试管中。如果要制作平板培养基或液体、半固体培养基,则须将培养基分装于锥形瓶内。
5、加棉塞
分装完毕后,需要用棉塞堵住管口或瓶口。堵棉塞的主要目的是过滤空气,避免污染。棉塞应采用普通新鲜、干燥的棉花制作,不要用脱脂棉,以免因脱脂棉吸水使棉塞无法使用。
6、制作斜面培养基和平板培养基
培养基灭菌后,如制作斜面培养基和平板培养基,须趁培养基未凝固时进行。
培养基操作步骤:
一、用法:称取本品33.0g,加热溶解于1000ml蒸馏水中,分装三角瓶,121℃高压灭菌15分钟,备用。
二、配料:首先,根据培养基的配方,准确称量各种成分,包括粉状和非粉状的成分,如肉膏等,放入烧杯中。
三、溶化:向烧杯中加入适量的水,然后搅拌以溶解各成分。对于含有琼脂的培养基,应注意防止外溢,并在溶化过程中保持搅拌。
四、矫正pH:在培养基溶解均匀并冷却至室温后,使用pH试纸测量pH值,然后根据需要加入酸或碱来调整至合适的pH值。
五、澄清过滤:使用滤纸或多层纱布对培养基进行过滤,以去除杂质。
六、分装:将制备好的培养基分装入试管内或三角瓶内,确保管(瓶)口塞上棉塞,以防止外界微生物污染。
七、灭菌:对分装好的培养基进行灭菌处理,通常是通过高压灭菌来确保无菌环境。
八、检定:灭菌后的培养基可以进行质量检定,以确保其符合使用要求。
公司正在出售的产品:
PAC3 人血小板相关补体3酶联免疫检测试剂盒 Rat omentin ELISA Kit,omentin,omentin
Papilin蛋白检测试剂盒 PAPLN 酶联免疫 Kit Rat anti erythrocyte antibody ELISA Kit,anti erythrocyte antibody,RBC
PEDF 人色素上皮衍生因子酶联免疫检测试剂盒 Rat Cytoglobin ELISA Kit,Cytoglobin,CYGB
PGF2α 大鼠前列腺素F2α酶联免疫检测试剂盒 Mouse N-terminal pro-brain natriuretic peptide ELISA Kit,N-terminal pro-brain natriuretic peptide,NT-proBNP
PLC 人磷酯酶C酶联免疫检测试剂盒 Mouse Interleukin 17 ELISA Kit,Interleukin 17,IL-17
PRL 小鼠催乳素酶联免疫检测试剂盒 Mouse cholesterol ELISA Kit,cholesterol,CH
PY 小鼠吡啶交联物酶联免疫检测试剂盒 Mouse Bone-specific Alkphase B ELISA Kit,Bone-specific Alkphase B,ALP-B
Repetin蛋白检测试剂盒 RPTN 酶联免疫 Kit Mouse basic fibroblast growth factor 9 ELISA Kit,basic fibroblast growth factor 9,bFGF-9
S-100 大鼠S100蛋白酶联免疫检测试剂盒 Mouse Immunoglobulin G ELISA Kit,Immunoglobulin G,IgG
sCD40L 大鼠可溶性白细胞分化抗原40配体酶联免疫检测试剂盒 Mouse NCAM-1;CD56 ELISA Kit,NCAM-1;CD56,NCAM-1;CD56
DO Supplement(五缺:Arg/His/Leu/Lys/Ura)SHC-转化蛋白1检测试剂盒 SHC1 酶联免疫 Kit Mouse Gastrin ELISA Kit,Gastrin,Gas
sMHC-1 小鼠可溶性肌球蛋白重链1酶联免疫检测试剂盒 Mouse Insulin ELISA Kit,Insulin,INS
sP-selectin 兔子可溶性P选择素酶联免疫检测试剂盒 Mouse Transforming Growth factor α ELISA Kit,Transforming Growth factor α,TGF-α
Synembryn蛋白检测试剂盒 SYN 酶联免疫 Kit Mouse fructosamine ELISA Kit,fructosamine,FRA
TAT 大鼠凝血酶抗凝血酶复合物酶联免疫检测试剂盒 Mouse leukemia inhibitory factor ELISA Kit,leukemia inhibitory factor,LIF
TFR/CD71 小鼠转铁蛋白受体酶联免疫检测试剂盒 Mouse WNT10B ELISA Kit,WNT10B,WNT10B
风险提示:丁香通仅作为第三方平台,为商家信息发布提供平台空间。用户咨询产品时请注意保护个人信息及财产安全,合理判断,谨慎选购商品,商家和用户对交易行为负责。对于医疗器械类产品,请先查证核实企业经营资质和医疗器械产品注册证情况。
技术资料暂无技术资料 索取技术资料
DO Supplement(五缺:Arg/His/Leu/Lys/Ura)
¥600 - 3200